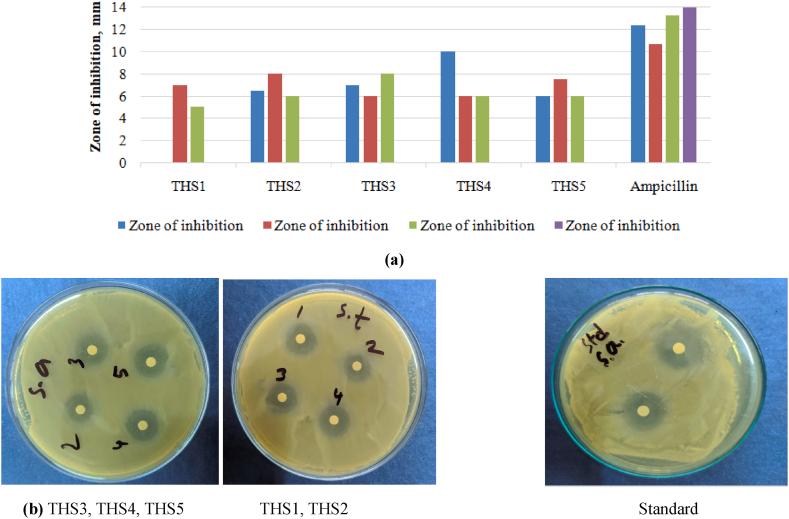

硫代氨基脲衍生物的合成、表征、抗菌活性及其计算方法:量子计算、分子对接、分子动力学、药物代谢动力学/药物毒性预测、定量构效关系
Synthesis, characterization, antibacterial activity of thiosemicarbazones derivatives and their computational approaches: Quantum calculation, molecular docking, molecular dynamic, ADMET, QSAR.
作者信息
Alam Mahbub, Abser Mohammed Nurul, Kumer Ajoy, Bhuiyan Md Mosharef Hossain, Akter Parul, Hossain Md Emdad, Chakma Unesco
机构信息
Inorganic Research Laboratory, Department of Chemistry, Jahangirnagar University, Savar, Dhaka, 1342, Bangladesh.
Laboratory of Computational Research for Drug Design and Material Science, Department of Chemistry, European University of Bangladesh, Dhaka, 1216, Bangladesh.
出版信息
Heliyon. 2023 May 24;9(6):e16222. doi: 10.1016/j.heliyon.2023.e16222. eCollection 2023 Jun.
The thiosemicarbazones and their derivatives have been recognized as antimicrobial agents against human pathogenic bacteria and fungi. Regarding these prospective, this study was designed to address the new antimicrobial agents from thiosemicarbazones and their derivatives. These derivatives were synthesized by multi-step synthesis methods, such as alkylation, acidification, esterification, and formed the 4-(4'-alkoxybenzoyloxy) thiosemicarbazones and its derivatives THS1, THS2, THS3, THS4, and THS5). Afterward the synthesis, compounds were characterized by H NMR, FTIR spectra, and melting point. Later, the computational tools were applied to evaluate the drug likeness properties, bioavailability score, Lipinski rule, absorption, distribution, metabolism, excretion, and toxicity (ADMET). Secondly, the quantum calculations, for instance HOMO, LUMO and chemical descriptors, were calculated by the density functional theory (DFT). Finally, the molecular docking was performed against seven human pathogenic bacteria, black fungus (Rhizomucor mieh, Mucor lusitanicus, Mycolicibacterium smegmatis) and white fungus strains (Candida Auris, Aspergillus luchuensis, Candida albicans). To check and validate of molecular docking procedure and stability of docked complex for ligand and protein, the molecular dynamic was performed of docked complex. From the docking score with calculating the binding affinity, these derivatives could show a higher affinity than standard drug against all pathogens. From the computational details, it could be decided to do test as antimicrobial activity against Staphylococcus aurious, Staphylococcus homonis, , and Shigella flexneria. The obtained result of antibacterial activity compared to standard drugs, and it was found that the synthesized compounds were almost same value of standard drug. Finally, it could be said from the and study that the thiosemicarbazones derivatives are good antimicrobial agents.
硫代氨基脲及其衍生物已被公认为是针对人类病原菌和真菌的抗菌剂。鉴于这些前景,本研究旨在探索来自硫代氨基脲及其衍生物的新型抗菌剂。这些衍生物通过多步合成方法制备,如烷基化、酸化、酯化,形成了4-(4'-烷氧基苯甲酰氧基)硫代氨基脲及其衍生物THS1、THS2、THS3、THS4和THS5。合成后,通过核磁共振氢谱(H NMR)、傅里叶变换红外光谱(FTIR)和熔点对化合物进行表征。随后,应用计算工具评估药物相似性性质、生物利用度评分、Lipinski规则、吸收、分布、代谢、排泄和毒性(ADMET)。其次,通过密度泛函理论(DFT)计算量子化学参数,如最高占据分子轨道(HOMO)、最低未占据分子轨道(LUMO)和化学描述符。最后,对七种人类病原菌、黑曲霉菌株(米根霉、葡萄牙毛霉、耻垢分枝杆菌)和白曲霉菌株(耳念珠菌、琉球曲霉、白色念珠菌)进行分子对接。为了检查和验证分子对接程序以及对接复合物中配体和蛋白质的稳定性,对对接复合物进行了分子动力学模拟。从计算结合亲和力的对接分数来看,这些衍生物对所有病原体的亲和力均高于标准药物。根据计算细节,决定对金黄色葡萄球菌、人葡萄球菌和弗氏志贺菌进行抗菌活性测试。将所得抗菌活性结果与标准药物进行比较,发现合成化合物的活性与标准药物几乎相同。最后,从本研究可以得出结论,硫代氨基脲衍生物是良好的抗菌剂。